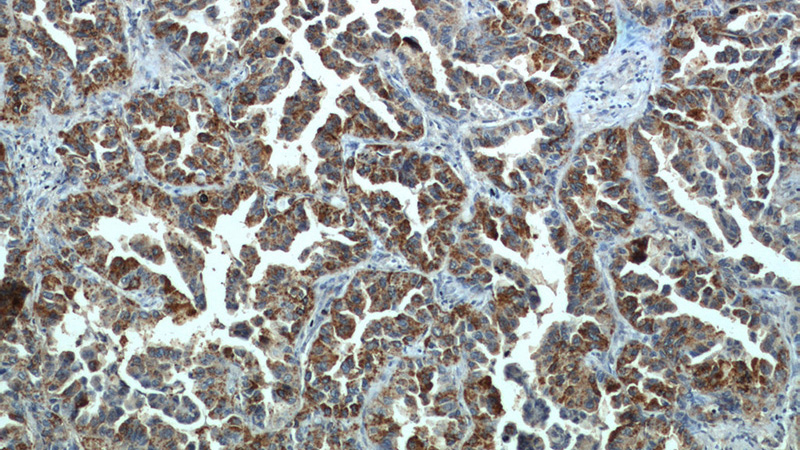
Immunohistochemistry of paraffin-embedded human lung cancer slide using Catalog No:112908(MX1 Antibody) at dilution of 1:50
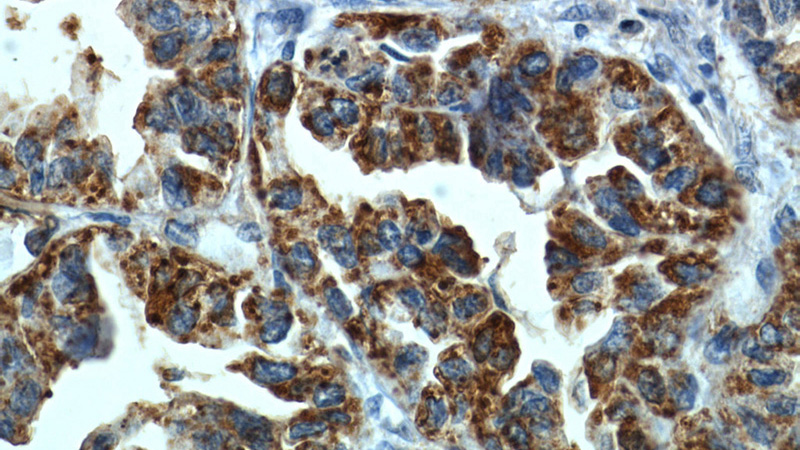
Immunohistochemistry of paraffin-embedded human lung cancer slide using Catalog No:112908(MX1 Antibody) at dilution of 1:50

-
Product Name
MX1 antibody
- Documents
-
Description
MX1 Rabbit Polyclonal antibody. Positive WB detected in mouse spleen tissue, A549 cells, mouse lung tissue, NIH/3T3 cells. Positive IP detected in A549 cells. Positive IHC detected in human lung cancer tissue, human tonsillitis tissue. Positive IF detected in A549 cells. Observed molecular weight by Western-blot: 76 kDa
-
Tested applications
ELISA, WB, IHC, IP, IF
-
Species reactivity
Human, Mouse; other species not tested.
-
Alternative names
IFI 78K antibody; IFI78 antibody; Interferon induced protein p78 antibody; MX1 antibody; MxA antibody; Myxovirus resistance protein 1 antibody
-
Isotype
Rabbit IgG
-
Preparation
This antibody was obtained by immunization of MX1 recombinant protein (Accession Number: XM_005260980). Purification method: Antigen affinity purified.
-
Clonality
Polyclonal
-
Formulation
PBS with 0.02% sodium azide and 50% glycerol pH 7.3.
-
Storage instructions
Store at -20℃. DO NOT ALIQUOT
-
Applications
Recommended Dilution:
WB: 1:200-1:2000
IP: N/AIHC: 1:20-1:200
IF: 1:20-1:200
-
Validations

mouse spleen tissue were subjected to SDS PAGE followed by western blot with Catalog No:112908(MX1 antibody) at dilution of 1:300

IP result of anti-MX1 (Catalog No:112908 for IP and Detection) with A549 cell.
Immunohistochemistry of paraffin-embedded human lung cancer slide using Catalog No:112908(MX1 Antibody) at dilution of 1:50
Immunohistochemistry of paraffin-embedded human lung cancer slide using Catalog No:112908(MX1 Antibody) at dilution of 1:50

Immunofluorescent analysis of (10% Formaldehyde) fixed A549 cells using Catalog No:112908(MX1 Antibody) at dilution of 1:50 and Alexa Fluor 488-congugated AffiniPure Goat Anti-Rabbit IgG(H+L)
-
Background
Mx1 (also known as MxA) is a GTPase that belongs to the Mx family of proteins, which are ubiquitous in eukaryotes and involved in the immune response to viral infections. The human Mx1 is localized in the cytoplasm interfering with the translation of viral proteins, whereas the mouse Mx1 accumulates in the nucleus and inhibits the primary transcription of viral RNA. Mx1 expression is induced by treatment with α/β interferon (INF). This antibody can recognize the endogenous Mx1 protein in several tissues like lung and spleen.
-
References
- Hoff F, Greb C, Hollmann C, Hönig E, Jacob R. The large GTPase Mx1 is involved in apical transport in MDCK cells. Traffic (Copenhagen, Denmark). 15(9):983-96. 2014.
- Brown SG, Knowell AE, Hunt A, Patel D, Bhosle S, Chaudhary J. Interferon inducible antiviral MxA is inversely associated with prostate cancer and regulates cell cycle, invasion and Docetaxel induced apoptosis. The Prostate. 75(3):266-79. 2015.
- An K, Fang L, Luo R. Quantitative proteomic analysis reveals that transmissible gastroenteritis virus activates the JAK-STAT1 signaling pathway. Journal of proteome research. 13(12):5376-90. 2014.
- Liu S, Peng N, Xie J. Human hepatitis B virus surface and e antigens inhibit major vault protein signaling in interferon induction pathways. Journal of hepatology. 62(5):1015-23. 2015.
- Bai L, Zhang W, Tan L. Hepatitis B virus hijacks CTHRC1 to evade host immunity and maintain replication. Journal of molecular cell biology. 7(6):543-56. 2015.
- Ouyang J, Zhu X, Chen Y. NRAV, a long noncoding RNA, modulates antiviral responses through suppression of interferon-stimulated gene transcription. Cell host & microbe. 16(5):616-26. 2014.
- Maria NI, van Helden-Meeuwsen CG, Brkic Z. Increased Tregs associated with elevated Indoleamine-2,3-dioxygenase activity and an imbalanced Kynurenine pathway in IFNpositive primary Sjögren's syndrome. Arthritis & rheumatology (Hoboken, N.J.). 2016.
- Yokogawa M, Takaishi M, Nakajima K. Epicutaneous application of toll-like receptor 7 agonists leads to systemic autoimmunity in wild-type mice: a new model of systemic Lupus erythematosus. Arthritis & rheumatology (Hoboken, N.J.). 66(3):694-706. 2014.
Related Products / Services
Please note: All products are "FOR RESEARCH USE ONLY AND ARE NOT INTENDED FOR DIAGNOSTIC OR THERAPEUTIC USE"
